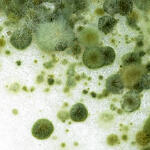
mold

the species that can be found in this menagerie of a system.
CLEMENTINE
physical wild cat.

cougar

snow leopard
Experiences rare transformations.

blue whale
BEAR
I am physically nonhuman and personally use the terms therian or holothere.
These species are the ones I experience physical shifts for. Because these shifts warp my perception of limb and body shape, block sensations like pain/cold and replace them with the sensation of the body part, and that I can feel my brain not fitting in my cranium, I believe this physical nonhumanity mostly involves my nervous system.

grizzly bear

black bear

blue whale
Here are my spiritual connections. They can contribute to physical shifts, but in general these are species I feel particularly spiritually connected to. I believe I share traits with them because our spiritual threads are wound together.

german shepherd

eastern carpenter bee
These species I have a psychological connection to. I believe these types formed during mental health episodes, or are directly connected to a specific mental state.

horse

chow chow
SATURN
non-christian angeliform; made up of many species and found in all of them.

doves

black-browed albatross

whale shark

crabeater seal

european mantis

north american porcupine

sphynx cat

sighthounds

horseshoe crab

venus fly trap

coelacanth

bell-shaped flowers

flashes in stone
OPHELIA
shapeshifter. favorite forms.
thog dont care about terminology

american alligator

tigers

domestic pig

leatherleaf slug

jaguars

burmese python

ball python

argentine black and white tegu

cicadas

alligator snapping turtle

coconut crab

moray eel

spider crab

shiba inu

hog badger

common spotted cuscus
ROME
Physical forms

central european boar

american badger

rot
Psychological otherkin

black eastern rat snake

german shepherd

doberman pinscher

polar bear

sperm whale

osprey
LILITH
otherkin!

fancy rat

black vulture
RARITY
physically unicorn

fancy rat
hearttypes

flying fish

betta fish

harp seal
ROACH

american cockroach

giant centipedes
mold